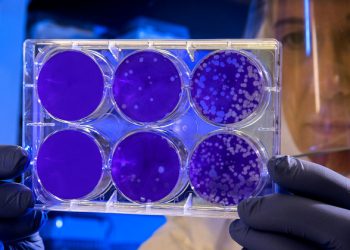
Follow the science: UN plans for a stronger pandemic recovery |

Sustainability
‘Make peace with nature’, UN chief urges at Ocean Decade launch |
UNESCO marked the start of the UN Decade of Ocean Science for Sustainable Development, with a global online event headlined:...
First Person: Digging for victory in the Philippines |
Louise Mabulo has been recognized as a prodigy of the culinary world since the age of 12, when she appeared...
Consecutive drop in new COVID-19 cases ‘encouraging news’: WHO |
“There are still many countries with increasing numbers of cases, but at the global level, this is encouraging news”, said...
Impact of COVID-19 on cancer care has been ‘profound’, warns UN health agency |
More than a year since the new coronavirus crisis began, its impact on cancer care has been stark, with “50 per...
Youth movement leads the charge worldwide for food systems transformation ahead of UN summit – United Nations Sustainable Development
Young activists and campaigners have mobilized alongside experts in women’s empowerment, human rights, finance, and innovation across multiple continents to...
Fair Finance: The women entrepreneurs lifting communities out of poverty |
Goodwill Ambassador Sonia Gardner. UNCDF Moroccan-born Ms. Gardner, is one of the most prominent senior women in the financial sector, and...
Hopes of fresh momentum in fight against leprosy, but stigmatization persists |
“We should learn from the history of leprosy. To better fight against an epidemic or a pandemic, we must eliminate...
FROM THE FIELD: Celebrating the power of centuries-old farming techniques |
The process of recovery from the coronavirus pandemic offers the chance to change course, and put humanity on a path...
Follow the science: UN plans for a stronger pandemic recovery |
In her remarks to the event, Ms. Mohammed noted the far-reaching social, economic, and health impacts of the pandemic, the...
WHO urges effective and fair use of COVID vaccines |
“More vaccines are being developed, approved and produced. There will be enough for everyone”, said Tedros Adhanom Ghebreyesus, the WHO...
POPULAR NEWS
Subscribe to get more!
© 2018 EcoBuild.club - All about Eco Friendly Environment !